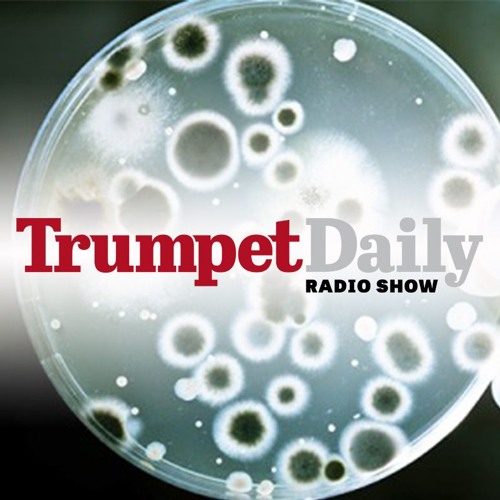

Science has become a god in our society. In today’s world, many carelessly accept what is produced from the scientific community as doctrine. Though, recent studies have revealed that in many areas of science, bias, flawed methodology, fraud and laziness have contributed to wrong conclusions. Yet many still carelessly believe what they read or hear, and any dissenters are cast out of the scientific community. How has modern science gotten so off base? On today’s show, Stephen Flurry explains what is at the core of this problem.
No comments:
Post a Comment